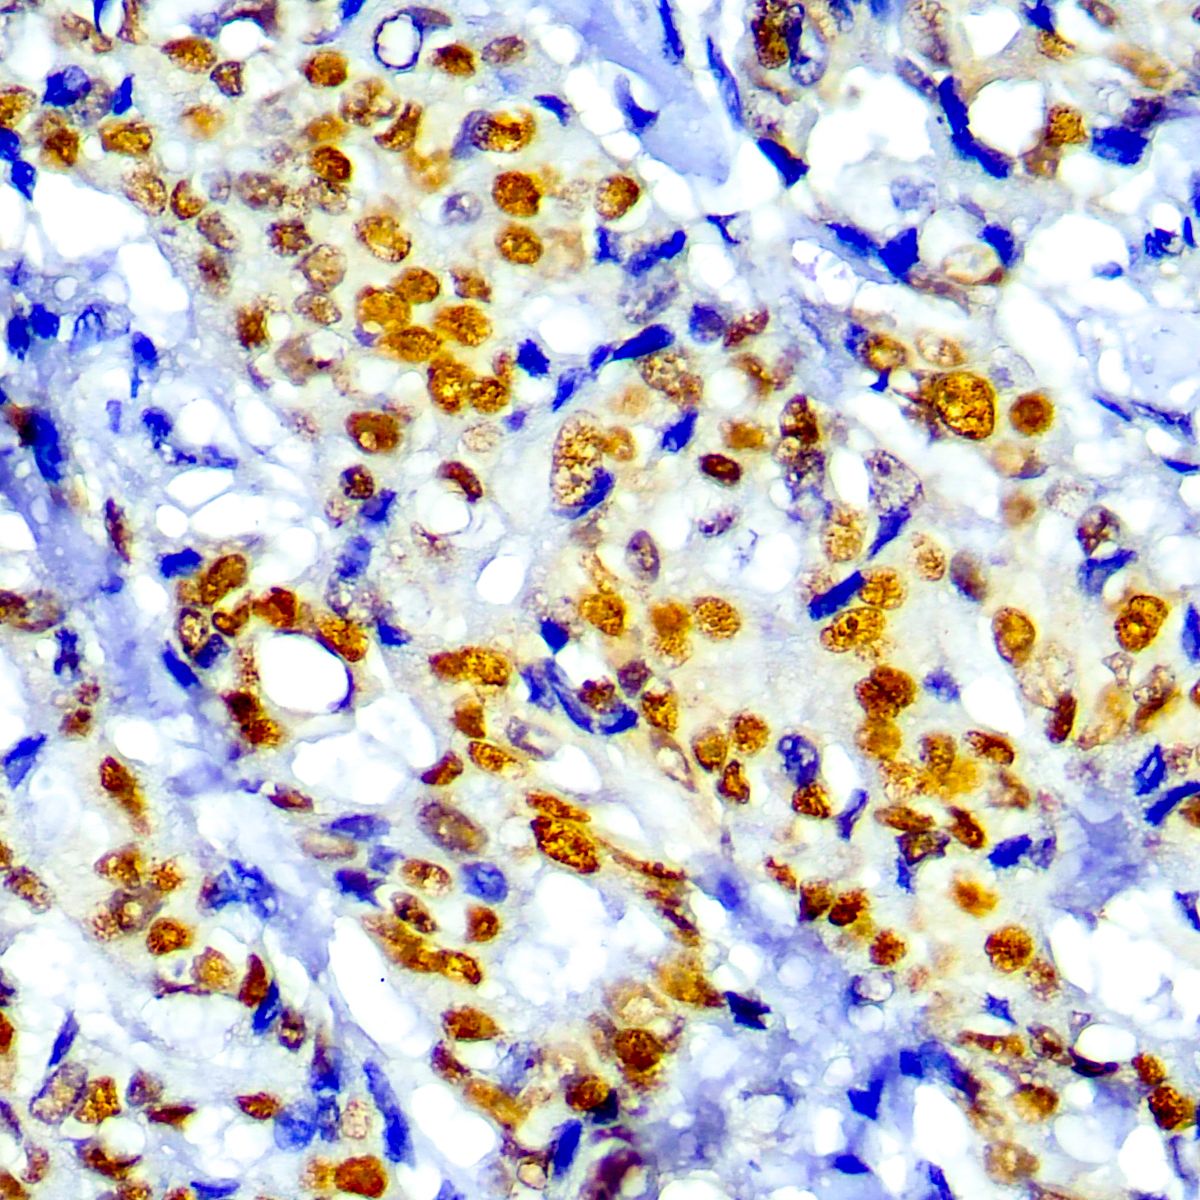

TRPS1, Trichorhinophalangeal syndrome type 1, is a recombinant rabbit monoclonal antibody that helps in the identification of breast carcinoma, invasive or in situ. It provides good values in differentiating between primary and metastatic breast carcinoma in various body sites. It has been reported 1-4 that TRPS1 and GATA3 had comparable positive expressions in ER-positive (98% vs. 95%) and HER2-positive (87% vs. 88%) breast carcinomas. However, TRPS1 was highly expressed in triple negative breast carcinoma (TNBC), and significantly higher than GATA3 expression in metaplastic (86% vs. 21%) and nonmetaplastic (86% vs. 51%) TNBC 1-4. In addition, TRPS1 expression was evaluated in more than 1000 cases of solid tumors from different organs 1-4. In contrast to the high expression of GATA3 in urothelial carcinoma, TRPS1 showed no or little expression in urothelial carcinomas or in other tumor types including lung adenocarcinoma, pancreatic adenocarcinoma, colon and gastric adenocarcinoma, renal cell carcinoma, melanoma, and ovarian carcinoma 1-4. These findings suggest that TRPS1 is a highly sensitive and specific marker for breast carcinoma and can be very useful in the identification of breast carcinoma, primary or metastatic, especially for TNBC.
TRPS1
Description
Additional information
| Catalog No. | RMAB114, RMAB114-01, RMAB114-05 |
|---|---|
| Clone | EPR16171 |
| Species | Rabbit |
| Isotype | IgG1, kappa |
| Immunogen | Recombinant human TRPS1 protein fragment |
| Positive Control Tissue | Breast carcinoma |
| Pretreatment | EDTA Buffer pH 8.0 (Manual/Montage) |
| Incubation & Temperature | 30 min @ RT |
| Intended Use | IVD (Outside Europe) |
| Detection System | PolyVue™ Plus – Two Step Detection System or Montage PolyVue Plus™ Auto Detection System for Montage 360 System |
| Format | This product is supplied as a tissue culture supernatant and contains sodium azide as a preservative. |
| Description/Type | Rabbit Monoclonal Antibody |
DATASHEETS & SDS
DATASHEETS & SDS
| Download Datasheet |
| Download SDS Sheet – OSHA |
REFERENCES
REFERENCES
i) Mod Pathol 2021;34:710
ii) Hum Pathol 2022;125:97
iii) Hum Pathol 2023;138:62
iv) Int J Cancer Biomed Res 2023;7:13
Reviews (0)
Only logged in customers who have purchased this product may leave a review.

Reviews
There are no reviews yet.